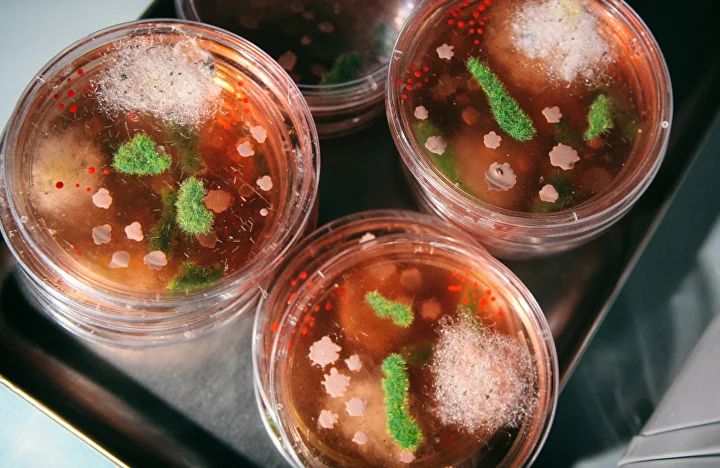

«Микромир» - шоу-программа для юных исследователей, которые мечтали оказаться внутри настоящей лаборатории и проводить захватывающие эксперименты с микроскопами, чашками Петри и реактивами. Погружаемся в невидимую глазу вселенную микроорганизмов и изучаем её под разными углами: от наблюдения за рачками под микроскопом до микробиологических посевов. Чашки Петри, микроскопы, химические реакции и целая вселенная микроорганизмов - всё это ждёт вашего ребёнка!


ЗА 2 ЧАСА ВАШ РЕБЕНОК:
1. Увидит, что микроорганизмы можно изучать не только с помощью микроскопа.
2. Сделает микробиологический посев почвы и выяснит, что не все микробы одинаково вредны.
3. Применит химический анализ к продуктам и узнает, что общего у йогурта и квашеной капусты.
4. Научится находить признаки жизни там, где, на первый взгляд, их нет.


КАК ВСЁ УСТРОЕНО
Дети делятся по возрастам на небольшие команды (по 5-6 детей). Каждая команда проводит по 20 минут в четырёх лабораториях, где ребята формулируют и проверяют гипотезы, ставят опыты и делают выводы. Программа полностью интерактивна - каждый ребёнок выполняет задания собственноручно.
Для родителей подготовлена увлекательная научная викторина.
Важно! Перед каждой программой проводится небольшой квест. Рекомендуем приходить за полчаса, чтобы успеть в нём поучаствовать.


ПРОГРАММА ДЛЯ ДЕТЕЙ 7–13 ЛЕТ
1. Лаборатория чашек Петри
Узнаем, кто живёт у нас под ногами: произведём смыв почвы, сделаем посевы и проанализируем, что там выросло.
2. Лаборатория предметных стекол
Познакомимся с дрожжами, поймаем углекислый газ, который они выделяют, научимся окрашивать и фиксировать микропрепараты.
3. Лаборатория микроскопов
Исследуем крошечных многоклеточных, рассмотрим ракообразных и инфузорий под оптическим и электронным микроскопами.
4. Лаборатория реактивов
Заставим микроорганизмы служить человеку: приготовим кефир, сравним кислотность продуктов и узнаем, что общего у молока и квашеной капусты.

ДЛЯ ДОШКОЛЬНИКОВ 5–6 ЛЕТ «Наука под микроскопом»
Отдельные маршруты с меньшими группами и большим количеством ведущих и ассистентов: каждый ребёнок получает максимум внимания. Эксперименты адаптированы под возраст и безопасны, но при этом увлекательны. Дети уменьшаются в масштабе, чтобы проникнуть в тайны микромира, рассмотрят привычные структуры под сильным увеличением и изучат строение растительной клетки.

БЕСПЛАТНАЯ ПРОГРАММА ДЛЯ РОДИТЕЛЕЙ
Пока дети путешествуют по лабораториям, взрослые могут принять участие в тематической научной викторине: 18 вопросов на эрудицию и логическое мышление, лекция-разбор правильных ответов, весёлые научные истории и специальный подарок победителю. В этот раз поговорим об археях, антибиотиках, ДНК и неожиданных способах применения бактерий в современной науке. Родители смогут обсудить свой опыт с ребёнком, дополнив впечатления от программы.
РАСПИСАНИЕ
• 15 марта, 11:00 – 5-6 и 7-10 лет
• 15 марта, 14:00 – 5-6, 7-10 и 11-13 лет
• 15 марта, 17:00 – 5-6, 7-10 и 11-13 лет
Продолжительность: 2 часа
БИЛЕТЫ
Стоимость билета (включая программу для родителей) – 60 AZN
Группы от 12 детей – 55 AZN за ребёнка
Вход для родителей бесплатный
Контакты для приобретения билетов: +994 50 716-57-87 (WhatsApp)
Место проведения: Imza, рядом со станцией метро Эльмляр